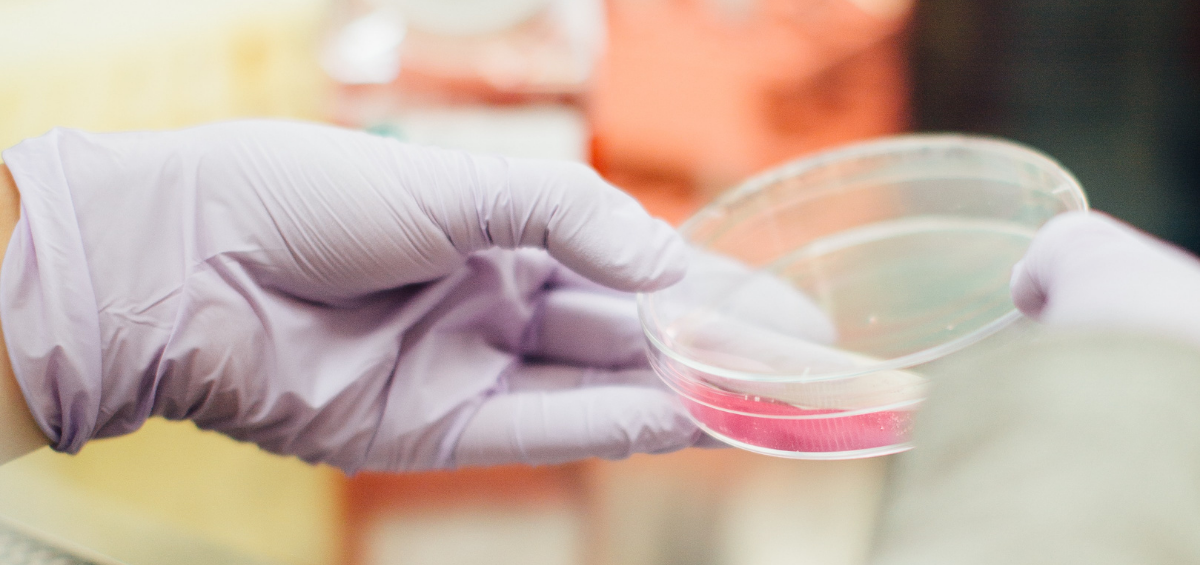

La Federación invita a empresas y startups tecnológicas innovadoras en el ámbito de la seguridad alimentaria a participar en el webinar Technological Innovation in Food Safety – From Solution to Business Model organizado en el marco del Proyecto Catalyse. La sesión online tendrá lugar el 12 de marzo, a las 10:00 h, y tendrá unaRead more
Blog
La Federación invita a los distintos actores de la cadena alimentaria a unirse a la Comunidad de práctica de Catalyse. La Federación Española de Industrias de Alimentación y Bebidas continúa promoviendo el desarrollo de soluciones innovadoras en materia de seguridad alimentaria a través del proyecto Catalyse, tras casi dos años de trabajo. El objetivo delRead more
La reunión de lanzamiento del proyecto DEFENSEFOOD, financiado por el programa Horizon Europe, tuvo lugar los días 13 y 14 de octubre en Wageningen (Países Bajos). Bajo el lema “Defendiendo los sistemas alimentarios a través de la ciencia y la innovación”, el proyecto busca fortalecer la prevención y capacidad de respuesta del sector anteRead more
Hoy 7 de junio, es el Día Mundial de la Seguridad Alimentaria y para la industria de alimentación y bebidas es un día muy importante puesto que nos recuerda el rol social tan relevante que ejercemos al formar parte del día a día de los ciudadanos, siendo responsables de proporcionar alimentos seguros que conforman laRead more
La industria de alimentación y bebidas trabaja a diario conocedores de la gran responsabilidad que supone proporcionar alimentos y bebidas que forman una parte importante de la dieta del consumidor. Sin duda, la seguridad alimentaria es uno de los compromisos fundamentales que requiere la participación activa y una mejora constante de todos los que formamosRead more
Hoy 7 de junio, es el Día Mundial de la Seguridad Alimentaria y para la industria de alimentación y bebidas es un día muy importante puesto que nos recuerda el rol social tan relevante que ejercemos al formar parte del día a día de los ciudadanos, siendo responsables de proporcionar alimentos seguros que conforman laRead more
Hoy celebramos el Día Mundial de la Seguridad Alimentaria y este año se cumplen 20 años del Reglamento (CE) n.º 178/2002 del Parlamento Europeo y del Consejo, de 28 de enero de 2002, por el que se establecen los principios y los requisitos generales de la legislación alimentaria, se crea la Autoridad Europea de SeguridadRead more
La empresa de higiene y desinfección continuará su alianza con FIAB y fruto de ella se estrenará como jurado del concurso Ecotrophelia 2022 sobre innovación alimentaria para estudiantes La Federación Española de Industrias de Alimentación y Bebidas (FIAB) y CLEANITY, compañía líder en soluciones de higiene industrial, han renovado su Convenio de colaboración, porRead more
La industria alimentaria utiliza cada día numerosos ingredientes tecnológicos en los alimentos y bebidas que pone a disposición de los consumidores. En su mayor parte, estos no dejan de ser un ingrediente más (aditivos, aromas, enzimas) que se añade a la preparación para mejorar su estabilidad, conservación y potenciar cualidades de la misma, como sabor,Read more
Imagen de Andrea Danti Los bacteriófagos (fagos) son virus bacterianos reconocidos como las formas de vida biológicas más diversas y abundantes. La población de fagos se estima en alrededor de 1031 en la biosfera y determina significativamente el número de bacterias en varios ecosistemas. En los años veinte del siglo XX, los primeros intentos deRead more